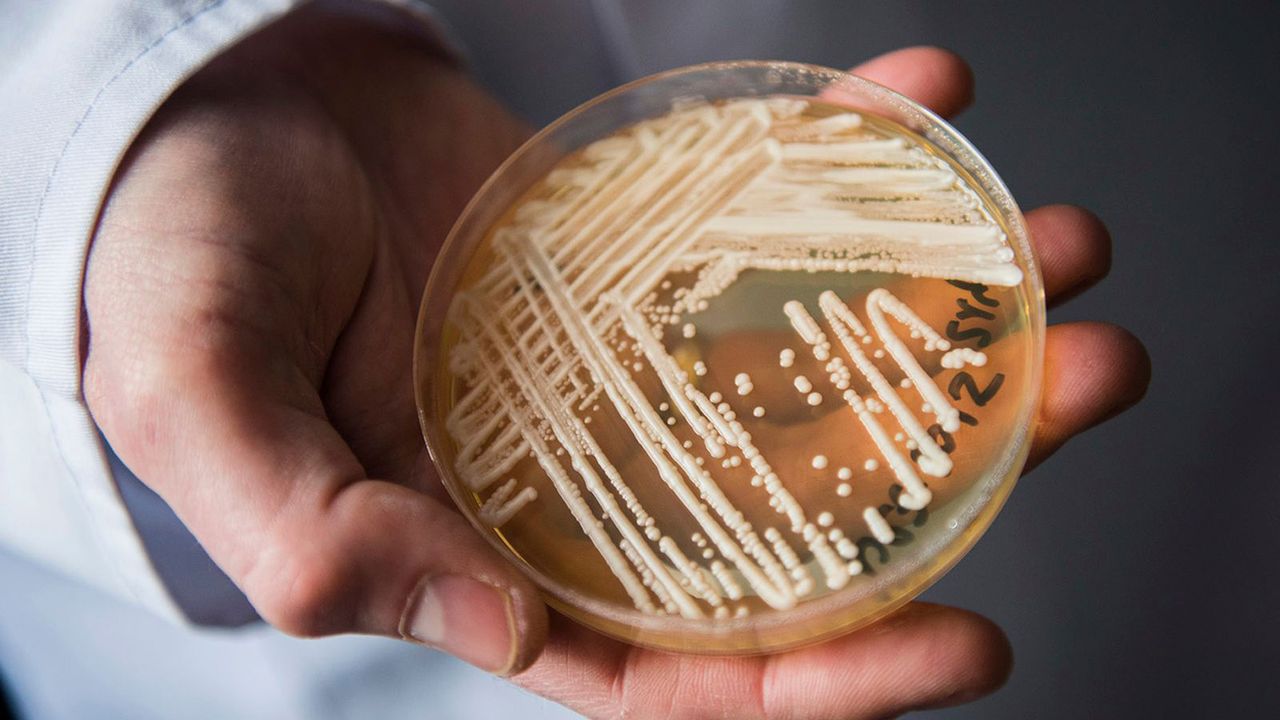

Yunanistan'da hastanelerde görülen candida auris mantarı vakalarında artış yaşanıyor.
Yunanistan Hastane Doktorları Federasyonu (OENGE) Başkan Yardımcısı Matina Pagoni, söz konusu mantarın özellikle yoğun bakım üniteleri ve bağışıklığı baskılanmış hastaların bulunduğu servislerde ortaya çıktığını açıkladı.
Pagoni, "Her yıl bu vakalarla karşılaşıyoruz. Ancak bu yıl Avrupa genelinde yüzde 60’lık artış var. Bu, tamamen hastane kaynaklı bir mantar." dedi.
Mantarın hem antiseptiklere hem de mantar ilaçlarına karşı dirençli olduğunu ifade eden Pagoni, hastanelere giriş ve çıkışlarda ellerin dikkatlice yıkanması gerektiğini kaydetti.
Candida auris, yüzeylerde ve tıbbi ekipmanlarda uzun süre canlı kalabilmesi nedeniyle kontrol altına alınması en zor mantarlar arasında yer alıyor. (İLKHA)